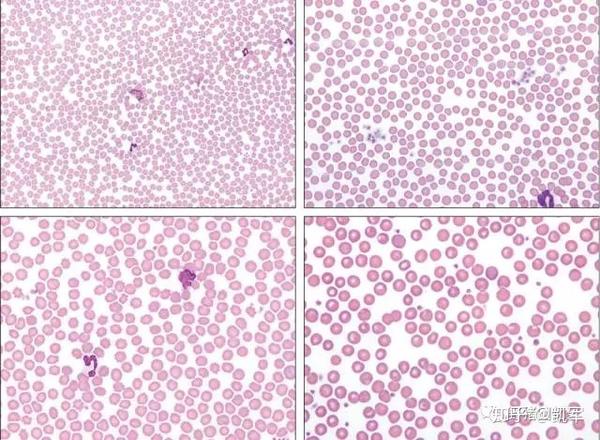
用40x的物镜可以对血涂片中的白细胞进行基本的判读,其数量是少,正常

正常血涂片

外周血片
图片尺寸2000x2000血涂片
图片尺寸1080x809
外周血片
图片尺寸2000x2000血涂片中正常血红细胞.
图片尺寸1200x847
形态学交流版〕正常外周血涂片
图片尺寸640x440血涂片
图片尺寸1080x810完美血涂片
图片尺寸1080x1057
血液涂片照片
图片尺寸294x300外周血涂片又跟大家分享学习啦
图片尺寸1080x810
外周血片
图片尺寸2000x2000
血涂片的制作ppt
图片尺寸1080x810
学涂片请教下面血涂片有原始细胞吗
图片尺寸3264x1840
用40x的物镜可以对血涂片中的白细胞进行基本的判读,其数量是少,正常
图片尺寸640x469
学涂片请教下面血涂片有原始细胞吗
图片尺寸3264x1840
结果如下:图1 ipu散点图界面门诊标本,5岁男性,健康查体,血常规散点
图片尺寸659x659
常见的血涂片图谱.ppt
图片尺寸1152x864
体检手册|血涂片
图片尺寸640x640
外周血片
图片尺寸2000x2000
放张血涂片镇楼,此人单纯疱疹就诊的
图片尺寸720x533血涂片.
图片尺寸1131x1100